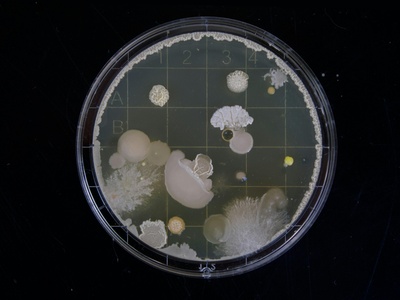
Petri Dish

Whether you’re equipping a teaching bench, a clinical lab, or a small research space, a clear inventory makes planning, safety and budgeting far easier. Thinking through what you need up front reduces downtime and helps teams work more efficiently.
There are 105 Examples of Laboratory Equipment, ranging from Agar Plates to pH Meter. For each item the list shows Category,Primary use,Typical specs (metric). You’ll find below.
How can I prioritize purchases when outfitting a new laboratory?
Start with essentials that affect safety and core workflows: personal protective equipment, basic glassware, accurate balances, and reliable incubators or refrigerators as required by your work. Use the Category and Primary use columns to group items into immediate, short-term, and long-term needs; the Typical specs (metric) column helps compare performance and compatibility so you avoid buying duplicates or incompatible equipment.
How should I use the “Typical specs (metric)” information when selecting equipment?
Treat those specs as common baseline values—use them to shortlist devices that meet your accuracy, capacity, and footprint requirements, then confirm exact tolerances and certifications with manufacturers. If you need different units, convert early and note any compatibility issues (power, fittings, consumables) before purchase.
Examples of Laboratory Equipment
| Name | Category | Primary use | Typical specs (metric) |
|---|---|---|---|
| Beaker | glassware | Holding, mixing, rough volume measurement | 50 mL–2,000 mL |
| Erlenmeyer Flask | glassware | Mixing, titration, culturing small volumes | 50 mL–2,000 mL |
| Volumetric Flask | glassware | Preparing precise standard solutions | 10 mL–2,000 mL |
| Graduated Cylinder | measurement | Measuring liquid volumes accurately | 10 mL–2,000 mL |
| Burette | measurement | Delivering precise titrant volumes | 10 mL–100 mL, ±0.05 mL |
| Pipette (air-displacement micropipette) | measurement | Dispensing small liquid volumes precisely | 0.1–1,000 µL, ±0.5–1.5% |
| Serological Pipette | consumables | Transferring milliliter volumes of liquid | 1 mL–50 mL |
| Pasteur Pipette | consumables | Transferring drops or small volumes | ~1 mL capacity glass or plastic |
| Pipette Tips | consumables | Disposable tips for micropipettes | 0.1–1,000 µL |
| Microcentrifuge Tube (Eppendorf tube) | consumables | Holding small samples for centrifugation | 0.2 mL–2.0 mL |
| Centrifuge (bench-top) | separation | Separating components by density | up to 15,000 rpm, rcf variable |
| Microcentrifuge | separation | High-speed spins for small tubes | up to 17,000 rpm, ≈25,000 × g |
| Refrigerated Centrifuge | separation | Cold centrifugation for temperature-sensitive samples | up to 20,000 rpm, ≥-20 °C |
| Vortex Mixer | support | Mixing small tubes by agitation | variable speed up to 3,000 rpm |
| Magnetic Stirrer | support | Continuous stirring of liquid solutions | stir bars for 10 mL–20 L, up to 1,500 rpm |
| Hotplate | thermal | Heating samples and stirring | up to 400 °C, variable power |
| Heating Mantle | thermal | Safe heating of round-bottom flasks | suitable for 50 mL–5,000 mL flasks, up to 450 °C |
| Bunsen Burner | thermal | Open flame heating and sterilization | adjustable flame up to ~1,500 °C |
| Water Bath | thermal | Incubating samples at steady temperatures | ambient+5 °C to 100 °C, various volumes |
| Dry Bath (heating block) | thermal | Heating tubes at fixed temperatures | blocks for 0.2–2,000 µL, up to 150 °C |
| Incubator (biological) | thermal | Controlled temperature growth for cultures | ambient+5 °C to 60 °C |
| Refrigerator (lab) | support | Cold storage for reagents and samples | 2–8 °C, various capacities |
| Freezer (ultra-low) | support | Long-term sample storage at very low temperature | -40 °C to -86 °C, various volumes |
| Liquid Nitrogen Dewar | support | Cryogenic storage and freezing | -196 °C capacity measured in liters |
| Cryovials | consumables | Secure sample storage at cryogenic temperatures | 0.5 mL–5.0 mL, cryo-rated |
| Autoclave | safety | Sterilization by high-pressure steam | 121 °C at 15 psi, cycles variable |
| Fume Hood | safety | Ventilated workspace for hazardous vapors | face velocity 0.3–0.5 m/s typical |
| Biosafety Cabinet (Class II) | safety | Protecting users and samples in biological work | ISO Class and airflow specs vary, 0.3–0.5 m/s |
| Eye Wash Station | safety | Emergency flushing of eyes after exposure | flow ≥1.5 L/min for 15 minutes |
| Safety Shower | safety | Full-body emergency decontamination | pull-activated, flow rate variable |
| Chemical Spill Kit | safety | Containment and cleanup of chemical spills | kit components variable by hazard class |
| Gloves (nitrile) | safety | Hand protection against chemicals and contamination | sizes S–XL, thickness 0.05–0.15 mm |
| Safety Goggles | safety | Protecting eyes from splashes and debris | indirect ventilation, impact-rated |
| Lab Coat | safety | Protective garment for clothing and skin | cotton or flame-resistant, sizes vary |
| Respirator (N95/half-mask) | safety | Respiratory protection against particulates/aerosols | filters rated per standard (e.g., N95) |
| Face Shield | safety | Full-face splash and impact protection | polycarbonate visor, adjustable headband |
| pH Meter | analytical | Measuring solution acidity/basicity | pH 0–14, ±0.01 pH accuracy |
| Analytical Balance | measurement | Measuring mass with high precision | readability 0.0001 g–0.01 g |
| Top-loading Balance | measurement | Weighing larger samples with moderate precision | readability 0.01 g–0.1 g, capacities varied |
| Spectrophotometer (UV-Vis) | analytical | Measuring absorbance of solutions | 200–800 nm, optical density units |
| Microplate Reader | analytical | High-throughput absorbance/fluorescence assays | 96/384-well plates, multiple modes |
| Fluorometer | analytical | Measuring fluorescence intensity of samples | wavelength ranges variable, high sensitivity |
| Mass Spectrometer | analytical | Measuring mass-to-charge ratios of ions | mass range variable, high resolution types exist |
| Gas Chromatograph (GC) | analytical | Separating volatile compounds for analysis | column temp up to 400 °C, flow rates mL/min |
| High-Performance Liquid Chromatography (HPLC) | analytical | Separating non-volatile compounds | flow 0.1–5.0 mL/min, pressure up to 600 bar |
| pH Electrode | measurement | Sensing hydrogen-ion concentration in solutions | glass electrode, typical length 120 mm |
| Thermometer (lab digital) | measurement | Measuring temperature in experiments | ±0.1 °C accuracy, probes variable length |
| Thermocouple/RTD | measurement | Accurate temperature sensing for systems | ranges ±0.1 °C, types K/J/E/T |
| pH Indicator Strips | consumables | Quick approximate pH checks | pH range patches 0–14 |
| Filter Paper | consumables | Filtration and particulate separation | pore sizes 2–10 µm common |
| Vacuum Pump | support | Creating vacuum for filtration and evaporation | flows varied, vacuum down to mbar |
| Rotary Evaporator (rotovap) | separation | Solvent removal under reduced pressure | rotary flask 50 mL–20 L, temp up to 200 °C |
| Vacuum Desiccator | support | Drying samples under low humidity | internal vacuum to mbar levels |
| Lyophilizer (freeze dryer) | separation | Drying samples by sublimation for preservation | sample capacity variable, vacuum and cooling stages |
| Ultrasonic Bath | support | Cleaning and disrupting samples with sound waves | frequency ~40 kHz, volumes variable |
| Sonicator (probe) | support | High-energy sonication for cell lysis | power tens to hundreds watts, probe sizes vary |
| Gel Electrophoresis Apparatus | analytical | Separating nucleic acids or proteins by size | gel size variable, voltage up to 300 V |
| UV Transilluminator/Blue Light Box | analytical | Visualizing nucleic acids in gels | UV 254–365 nm or blue 470 nm |
| PCR Thermal Cycler | analytical | Amplifying DNA via temperature cycling | blocks for 96 wells, temp range ±0.1 °C |
| PCR Hood (clean bench) | safety | Contamination-controlled setup for PCR prep | HEPA-filtered, UV light optional |
| Microplate (96-well) | consumables | High-throughput assays and sample reactions | 96 wells, volumes 0.2–0.3 mL per well |
| Microtome | support | Cutting thin sections for microscopy | section thickness 0.5–100 µm |
| Cryostat | support | Sectioning frozen tissue for histology | -20 °C to -30 °C chamber temps |
| Autopipettor Rack/Tip Box | support | Organizing pipettes and tips on bench | holds multiple pipettes or tips |
| Glassware Wash Bottle | consumables | Dispensing rinsing liquids safely | 250 mL common, squeeze bottle |
| Serological Bottle/Media Bottle | glassware | Storing and dispensing sterile media | 100 mL–2,000 mL, glass or PET |
| Bottle-top Dispenser | support | Dispensing repeatable liquid volumes from bottles | 0.5 mL–50 mL per dispense |
| Cell Culture Flask | consumables | Growing adherent cells in vitro | T25–T175 cm² surface area |
| Hemocytometer | measurement | Manual cell counting under microscope | counting grid 0.01 mm² squares |
| Colony Counter | support | Counting microbial colonies on plates | manual or digital, supports petri sizes |
| Petri Dish | consumables | Growing microbial cultures or assays | 35 mm–150 mm diameter |
| Agar Plates | consumables | Solid growth media for microorganisms | various media, standard 90–100 mm plates |
| Disposable Syringe | consumables | Dispensing and aspirating liquids | 0.5 mL–60 mL sizes |
| Needles and Needles Disposal (Sharps) | safety | Performing injections and safe disposal | gauge varies, sharps boxes must be puncture-resistant |
| Sterile Filters (syringe or membrane) | separation | Clarifying or sterilizing liquids by filtration | pore sizes 0.2 µm and 0.45 µm |
| Filter Flask (Buchner setup) | separation | Vacuum-assisted filtration with flasks | 250 mL–2,000 mL with sidearm |
| Büchner Funnel | separation | Vacuum filtration of solids from liquids | porcelain or plastic, various diameters |
| Desiccant (silica gel) | consumables | Moisture adsorption for storage and drying | packets grams variable, silica beads |
| Labeling Tape/Markers (lab-grade) | consumables | Durable sample and container labeling | temperature-resistant tapes and solvent markers |
| Rack (tube rack) | support | Organizing tubes and vials on bench | holds common tube sizes (0.2–50 mL) |
| First Aid Kit | safety | Treating minor injuries in lab settings | contents per workplace standards |
| Calibration Weights | support | Calibrating balances to ensure accuracy | class weights grams to kilograms |
| Incubated Shaker | support | Agitated incubation for cultures | temp ambient+5 °C to 50 °C, shaking up to 300 rpm |
| Orbital Shaker | support | Gentle mixing of flasks and plates | orbit diameters 2–50 mm, speeds up to 300 rpm |
| Protein Electrophoresis Tank (SDS-PAGE) | analytical | Separating proteins by molecular weight | gel sizes variable, voltage 50–250 V |
| Staining/Destaining Station | support | Dyeing gels or blots for visualization | containers for liquid handling |
| Cold Room | support | Large-scale temperature-controlled storage | 2–8 °C rooms, size varies |
| Label Printer (lab-grade) | support | Printing durable sample labels | thermal transfer or laser, label widths mm |
| pH Buffers (equipment accessory) | support | Standards for meter calibration | buffers at pH 4.00, 7.00, 10.00 |
| Waste Containers (chemical/biological) | safety | Collecting and segregating lab waste | labeled containers per waste class |
| Lab Notebook (bound) | support | Recording experimental observations and data | hardbound or electronic-compliant sizes |
| Autoclave Tape | consumables | Indicating successful sterilization on packages | temperatures up to 121 °C, indicator strip |
| Tape (PARAFILM) | consumables | Sealing vessels and plates for storage | stretch film width variable, flexible |
| Electrodes and Probes (sensors) | analytical | Measuring chemical or physical parameters | varies by analyte: conductivity, DO, etc. |
| Hot Air Oven | thermal | Drying and sterilizing glassware and instruments | temperatures up to 250 °C, controlled |
| Muffle Furnace | thermal | High-temperature ashing and heat treatment | up to 1,200 °C |
| Rocking Platform | support | Gentle rocking mixing for blots and gels | variable speed and tilt |
| Tongs and Forceps | support | Handling hot or sterile items | stainless steel, various lengths |
| Cryogenic Gloves | safety | Protecting hands from extreme cold | -196 °C rated for LN2 handling |
| Gas Regulator | support | Controlling gas flow from cylinders | pressure ratings bar or psi |
| Anaerobic Chamber | support | Creating oxygen-free environments for cultures | controlled O2 <1%, glove ports |
| Vacuum Oven | thermal | Drying under controlled heat and vacuum | temp up to 200 °C, vacuum mbar |
| Laminar Flow Hood (Class I/II variance) | safety | Particle-free workspace for assembly | HEPA-filtered laminar airflow specs vary |
| Orbital Incubator | thermal | Shaking incubation for microbial cultures | temp ambient+5 °C to 60 °C, up to 300 rpm |
Images and Descriptions

Beaker
Versatile cylindrical glass or plastic vessel used for mixing, heating, and rough volume estimates. Common in chemistry and teaching labs; borosilicate glass models resist thermal shock. Not for precise measurements—use proper glassware for accuracy and safety around heat.

Erlenmeyer Flask
Conical glass flask with narrow neck used to mix by swirling, perform titrations, or culture microbes. Popular in teaching and research; borosilicate versions withstand heating. Narrow neck reduces splashes and evaporation compared to beakers.

Volumetric Flask
Calibrated glass flask with a single fill mark for highly accurate solution preparation. Common in analytical labs for standards and dilutions; Class A models offer the best tolerance and traceable accuracy for quantitative work.

Graduated Cylinder
Tall, narrow cylinder with graduations for measuring liquid volumes more accurately than beakers. Plastic or glass versions exist; choose Class A glass for analytical tasks. Avoid using for critical volumetry—use volumetric flasks instead.

Burette
Long glass tube with stopcock for controlled titrant delivery during titrations. Common in analytical and teaching labs; high-precision glass burettes (Class A) provide fine volume control and low dead volume for accurate endpoints.

Pipette (air-displacement micropipette)
Adjustable micropipettes for precise microvolume transfer in molecular biology and chemistry. Models like P20, P200, P1,000 are standard. Use calibrated tips and regular calibration to maintain accuracy and avoid cross-contamination.

Serological Pipette
Long plastic or glass pipettes used with mechanical pipettors to transfer cell culture media and reagents. Sterile, disposable variants are common in tissue culture; graduated marks allow approximate volume control.

Pasteur Pipette
Simple glass or plastic transfer pipettes used for dropwise dispensing and non-critical transfers. Inexpensive and often disposable; glass Pasteur pipettes can be flame-sterilized but require care handling sharp ends.

Pipette Tips
Sterile, disposable tips that attach to micropipettes to prevent contamination. Filter tips reduce aerosol carryover for sensitive assays. Available in low-retention and calibrated varieties to improve accuracy in molecular workflows.

Microcentrifuge Tube (Eppendorf tube)
Small polypropylene tubes for sample storage, reactions, and microcentrifugation. Widely used in molecular biology; cryo-rated variants withstand low temperatures. Caps seal tightly to prevent leaks during spinning.

Centrifuge (bench-top)
Benchtop centrifuges spin samples to separate solids from liquids or fractions by density. Used across biology, clinical, and chemistry labs. Rotor type determines tube compatibility; balance samples to prevent damage or accidents.

Microcentrifuge
Compact centrifuge for microtubes used in molecular biology to pellet DNA, proteins, and debris. Fast acceleration and braking, often refrigerated models exist. Close rotor lid and balance to ensure safety.

Refrigerated Centrifuge
Centrifuge with temperature control to protect heat-sensitive biomolecules during high-speed spins. Essential for proteomics and clinical labs; maintain proper seals and service cooling system regularly.

Vortex Mixer
Handy device that rapidly agitates samples in tubes or microplates for mixing. Used in virtually all wet labs; adjustable speed and cup attachments increase versatility. Avoid running open centrifuge tubes unsecured.

Magnetic Stirrer
Device that uses a rotating magnetic field to spin a stir bar inside a vessel for homogeneous mixing. Often combined with heating (hotplate stirrer) for reactions. Not for viscous mixtures without stronger motors.

Hotplate
Flat heated surface to warm vessels, often with integrated stirring. Used in chemistry and prep labs for heating flasks and beakers. Use heat-resistant glassware and avoid oil baths without proper equipment.

Heating Mantle
Fabric-lined heating device that evenly heats round-bottom flasks for distillations and reflux. Safer than open flames; many have built-in thermostats. Use with proper clamps and insulation.

Bunsen Burner
Gas burner used for flame sterilization, heating, and flame tests in teaching and microbial labs. Requires laboratory gas supply and flame safety procedures; many institutions restrict use for safety reasons.

Water Bath
Thermostatted bath for gentle, uniform heating of samples in tubes or flasks. Used in biochemistry and microbiology; shaking water baths add agitation for improved mixing and oxygenation.

Dry Bath (heating block)
Compact heated block for PCR tubes, microcentrifuge tubes, and vials providing stable incubation temperatures. Safer than open flame and useful for enzyme reactions, incubations, and sample thawing.

Incubator (biological)
Temperature-controlled chamber used for microbial and cell culture growth. CO2-controlled variants maintain pH for mammalian cells. Regular cleaning and proper sterile technique prevent contamination risks.

Refrigerator (lab)
Laboratory-grade refrigerator for storing reagents, enzymes, and biological samples at controlled cool temperatures. Features alarms and locks for sample security. Not suitable for long-term sample preservation like freezers.

Freezer (ultra-low)
Ultra-low temperature freezers store DNA, enzymes, and samples at very cold temperatures for long-term preservation. Consume high energy; require maintenance and backup plans for sample security in case of failures.

Liquid Nitrogen Dewar
Insulated vessel for storing liquid nitrogen used to freeze and store biological samples. Common in biobanks and cryopreservation; extreme cold demands cryo-gloves and training to avoid frostbite.

Cryovials
Screw-cap tubes designed for liquid nitrogen storage with durable construction and low gas permeability. Used for long-term storage of cells and tissues; label with cryo-safe markers and racks.

Autoclave
Steam sterilizer used to decontaminate media, instruments, and biohazardous waste. Common in clinical, research, and teaching labs. Follow load guidelines and allow cooling before opening to prevent burns and pressure hazards.

Fume Hood
Enclosed ventilated bench protecting users from hazardous fumes and volatile chemicals. Essential for chemistry labs; check sash positioning and airflow monitors. Not a substitute for respiratory protection when required.

Biosafety Cabinet (Class II)
HEPA-filtered cabinet providing personnel, product, and environmental protection when handling biological agents. Required for tissue culture and certain microbiology workflows; regular certification is mandatory.

Eye Wash Station
Plumbed or portable station that provides continuous flushing for chemical or particle eye exposure. Required in labs handling hazardous chemicals; trains staff on location and operation for emergencies.

Safety Shower
Overhead shower for decontaminating skin/clothing after large chemical exposures. Common in labs handling corrosives; ensure unobstructed access and regular maintenance.

Chemical Spill Kit
Prepacked kits with neutralizers, absorbents, PPE, and disposal bags for addressing hazardous spills. Tailor contents to chemicals used; staff must be trained in use and waste disposal procedures.

Gloves (nitrile)
Disposable nitrile gloves resist many chemicals and punctures, commonly used in labs. Select appropriate glove type and thickness for chemical compatibility; double-glove for highly hazardous tasks.

Safety Goggles
Enclosed eye protection that seals around the eyes to prevent chemical splashes and flying particles. Essential PPE in wet labs; impact-rated models protect against mechanical hazards.

Lab Coat
Worn to protect personal clothing and skin from spills and contamination. Disposable or reusable; flame-resistant coats are recommended when fire or heat hazards are present. Remove before leaving lab.

Respirator (N95/half-mask)
Used when airborne hazards exceed safe levels or during aerosol-generating procedures. Choose appropriate type (filtering facepiece, elastomeric) and ensure fit testing and training for effective protection.

Face Shield
Clear shield protecting face from splashes, particulates, and debris during procedures or decontamination. Use with goggles for added eye protection during high-risk tasks.

pH Meter
Electrode-based instrument providing precise pH readings for buffers, media, and reactions. Regular calibration with standard buffers and proper electrode maintenance are essential for reliable results.

Analytical Balance
High-precision balance for weighing small masses in analytical chemistry and formulations. Draft shields, level adjustments, and calibration weights ensure accuracy. Use on vibration-free surfaces for best performance.

Top-loading Balance
Convenient balance for routine weighing tasks with faster readouts and larger capacity than analytical balances. Suitable for prep labs and inventory tasks; less precise than analytical models.

Spectrophotometer (UV-Vis)
Instrument that measures light absorbance/transmittance across UV-visible wavelengths for concentration determinations in chemistry and biology. Cuvette-based and plate-reader formats exist; pathlength affects quantitation accuracy.

Microplate Reader
Multimode reader measuring absorbance, fluorescence, and luminescence in microplates for ELISAs, kinetics, and screens. Useful in biotech and clinical labs; compatible with standard plate formats.

Fluorometer
Sensitive instrument detecting fluorescent signals for assays like DNA quantification and reporter assays. Requires appropriate dyes and careful blanking; some handheld models exist for fieldwork.

Mass Spectrometer
Powerful analytical instrument for identifying compounds by mass and structure. Used in proteomics, metabolomics, and environmental analysis. Requires trained operators and controlled lab infrastructure.

Gas Chromatograph (GC)
Chromatography system for separating and analyzing volatile organics. Often coupled to MS detectors for identification. Column selection and temperature programming determine separation performance.

High-Performance Liquid Chromatography (HPLC)
Liquid-phase separation using columns and detectors for quantifying pharmaceuticals, metabolites, and impurities. Requires solvents, degassing, and regular column maintenance for reproducible results.

pH Electrode
Probe used with pH meters to measure acidity; requires calibration and proper storage (storage solution) to maintain responsiveness. Replace if drift or slow response observed.

Thermometer (lab digital)
Digital thermometers with probes for monitoring baths, incubators, and reactions. Fast response and readability make them standard; use appropriate range sensor for target temperatures.

Thermocouple/RTD
Robust temperature probes used in industrial and research equipment for precise control. RTDs offer stability while thermocouples cover wide ranges; select sensor type per application.

pH Indicator Strips
Paper strips with color scales for rapid, approximate pH estimation of solutions. Useful for field checks and routine tasks but not substitute for pH meters when precision is needed.

Filter Paper
Porous paper used with funnels for gravity filtration in chemistry and sample clarification. Choose pore size and grade matching application; folded or quantitative papers serve different purposes.

Vacuum Pump
Pump used with filtration manifolds, rotary evaporators, and dessicators to provide suction. Oil-sealed and oil-free types vary in maintenance needs; trap solvents to protect pump.

Rotary Evaporator (rotovap)
Apparatus for gentle solvent evaporation using rotation, vacuum, and heating bath. Common in organic chemistry for concentrating extracts; proper glassware assembly and cold trap use are important.

Vacuum Desiccator
Sealed chamber used with desiccants and vacuum to dry samples and remove moisture. Useful for moisture-sensitive materials; avoid placing volatile compounds inside without containment.

Lyophilizer (freeze dryer)
Freeze-dryer removes water by freezing and vacuum sublimation to preserve biomolecules and powders. Common in pharmaceuticals and labs preparing stable samples for storage or transport.

Ultrasonic Bath
Device that uses ultrasound to clean glassware or promote cell lysis and dispersion. Useful for gentle cleaning and mixing; avoid heating flammable solvents in ultrasonic baths.

Sonicator (probe)
Direct probe sonicators deliver focused ultrasonic energy for efficient cell disruption and emulsification. Powerful tool requiring hearing and splash protection due to aerosols and heat.

Gel Electrophoresis Apparatus
Chamber and power supply for running DNA, RNA, or protein gels. Common in molecular biology; UV or blue-light visualization follows staining. Use shielded power supplies and anti-UV precautions.

UV Transilluminator/Blue Light Box
Light source for imaging stained nucleic acid or protein gels. Blue-light boxes reduce DNA damage compared to UV for downstream applications; use goggles and minimize exposure.

PCR Thermal Cycler
Machine that precisely cycles temperatures for polymerase chain reaction in molecular biology. Gradient blocks enable primer optimization; proper sealing and contamination controls are essential.

PCR Hood (clean bench)
Small enclosed workspace with filtered airflow to reduce DNA/RNA contamination during PCR setup. Routinely decontaminate and avoid placing post-PCR products inside to prevent amplicon contamination.

Microplate (96-well)
Standard plastic plates used for ELISA, screening, and enzymatic assays. Available in various surface treatments and well volumes; match plate type to assay detection method for best results.

Microtome
Instrument that slices thin tissue sections for histology and microscopy. Rotary and cryostat microtomes differ by application; sharp blades and careful handling reduce artifacts and injury risk.

Cryostat
Cold microtome for cutting thin frozen tissue sections at controlled temperatures. Used in pathology and research for rapid sectioning; operators must use blade guards and cryo-safety protocols.

Autopipettor Rack/Tip Box
Racks and boxes designed to store and dispense pipette tips or holders for pipettes. Keeps workspace organized and reduces contamination; sterile tip racks are common consumables in molecular labs.

Glassware Wash Bottle
Plastic bottle with angled nozzle for rinsing glassware with water or solvents. Lab-grade bottles tolerate solvents and provide controlled rinsing; label contents clearly to avoid misuse.

Serological Bottle/Media Bottle
Sterile bottles used for preparing and storing cell culture media, buffers, and solutions. Autoclavable glass versions are common; screw-cap types enable aseptic transfers with bottle-top dispensers.

Bottle-top Dispenser
Pump-like dispenser mounts on reagent bottles to deliver consistent aliquots. Useful for acids, bases, and media; reduces repetitive pipetting and exposure to hazardous liquids.

Cell Culture Flask
Sterile flasks with vented caps used for maintaining adherent mammalian cell cultures. Treated surfaces promote cell attachment; incubator and sterile technique required to avoid contamination.

Hemocytometer
Glass slide with etched grid used to manually count cells or particles under a microscope. Low-cost and reliable for viability counts; requires dilution and careful pipetting to be accurate.

Colony Counter
Device or software-assisted table for counting colonies on agar plates. Saves time and improves reproducibility in microbiology; simple manual counters remain common in teaching labs.
Petri Dish
Shallow round dish used to culture microbes on agar or organize sample handling. Sterile disposable plastic plates are standard; glass versions exist for reusable applications. Stack carefully to avoid contamination.

Agar Plates
Prepared plates containing agar medium used to culture bacteria and fungi for diagnostics and research. Store inverted to prevent condensation; handle under sterile conditions to avoid contamination.

Disposable Syringe
Plastic syringes used in labs for accurate liquid transfer, filtration, and sample injection into instruments. Luer-lock tips ensure secure attachment to needles or adapters; choose appropriate syringe material for solvents.

Needles and Needles Disposal (Sharps)
Hypodermic needles are used in labs for precise liquid handling and sampling; require strict sharps disposal in labeled containers to prevent injury and contamination.

Sterile Filters (syringe or membrane)
Disposable membrane filters remove particulates and microbes from solutions. Common in sterile filtration of buffers and media; choose compatibility with solvents and sample volumes.

Filter Flask (Buchner setup)
Thick-walled flask with sidearm used in vacuum filtration setups with Büchner funnels for rapid separation. Use trap to protect vacuum pump from liquids and aerosols.

Büchner Funnel
Porous funnel used with filter paper for vacuum filtration of precipitates. Porcelain models are durable; match funnel size to flask and vacuum capacity for efficient filtration.

Desiccant (silica gel)
Silica or molecular sieve packets used to keep samples and reagents dry in storage. Common in sample shipping and storage; replace or regenerate when moisture indicator shows saturation.

Labeling Tape/Markers (lab-grade)
Specialized tapes and markers resist low temperatures and solvents for reliable labeling of tubes, vials, and racks. Proper labeling supports traceability and safe inventory management.

Rack (tube rack)
Plastic or metal racks that store microtubes, cryovials, and centrifuge tubes during experiments. Keeps samples upright and organized; cryo-racks designed for low-temperature compatibility.

First Aid Kit
Stocked kit for addressing minor cuts, burns, and exposures while awaiting medical help. Should be easily accessible and tailored to lab hazards; include burn dressings and eye irrigation adjuncts.

Calibration Weights
Traceable masses used to calibrate analytical and top-loading balances. Regular calibration maintains measurement integrity for quantitative labs and compliant record-keeping.

Incubated Shaker
Combines temperature control and orbital shaking to grow microbial and cell cultures with aeration. Useful for expression studies and growth optimization; ensure proper sealing to prevent spills.

Orbital Shaker
Platform that gently orbits to mix cultures or solutions, ideal for bacterial culture growth and hybridizations. Use clamps or platforms to secure flasks and plates during operation.

Protein Electrophoresis Tank (SDS-PAGE)
Apparatus for running protein gels using SDS-PAGE for analysis and purification checks. Requires power supply and staining/destaining steps; proper disposal of acrylamide is required due to toxicity.

Staining/Destaining Station
Trays and mixers for staining gels or membranes with Coomassie, silver stain, or dyes. Proper waste handling is important due to hazardous chemicals used in staining protocols.

Cold Room
Walk-in refrigerated room for bulk reagent and sample storage where refrigeration capacity exceeds benchtop units. Requires access control and monitoring to protect cold chain and inventory.

Label Printer (lab-grade)
Compact printers designed for lab labels resistant to chemicals and low temperatures. Improve traceability and reduce hand-label errors; use compatible label materials for cryogenic or solvent exposure.

pH Buffers (equipment accessory)
Pre-made buffer solutions used to calibrate pH meters regularly. Accurate calibration is essential for reliable measurements; store sealed and replace periodically to avoid drift.

Waste Containers (chemical/biological)
Specialized bins for sharps, chemical, biohazard, and solvent wastes facilitating compliant disposal. Clear labeling and segregation prevent cross-contamination and ensure regulatory adherence.

Lab Notebook (bound)
Durable bound notebooks used for chronological documentation of experiments, protocols, and results. Essential for reproducibility and intellectual property; record entries in ink and sign/date pages.

Autoclave Tape
Adhesive tape with heat-sensitive stripes that change appearance after autoclaving. Useful for quick visual confirmation of exposure; not a substitute for biological indicators for validation.

Tape (PARAFILM)
Parafilm is a flexible sealing film used to close flasks, tubes, and plates to prevent evaporation and contamination. Widely used in labs; not chemical proof for all solvents.

Electrodes and Probes (sensors)
Specialized probes measure conductivity, dissolved oxygen, ORP, and other parameters in solutions. Require calibration and maintenance; used in environmental, clinical, and process labs for monitoring.

Hot Air Oven
Convection oven used for drying glassware and heat-stable sterilization. Suitable for moisture removal and curing tasks; slower than autoclaving for sterilization of heat-sensitive items.

Muffle Furnace
High-temperature oven used for calcination, ashing, and material testing. Common in materials science and analytical labs; requires refractory chamber and proper ventilation for fumes.

Rocking Platform
Used for gentle agitation during staining, hybridization, and washing steps in assays. Provides even mixing for flat vessels; low-speed motion reduces risk of spillover.

Tongs and Forceps
Metal tools for manipulating glassware, samples, and sterile materials. Autoclavable and chemically resistant; use appropriate grip type and PPE when handling hot or contaminated items.

Cryogenic Gloves
Insulated gloves designed for handling cryogenic vessels and samples. Use in pairs and with forearm protection; not a substitute for general-purpose gloves during chemical handling.

Gas Regulator
Device that reduces and regulates pressure from compressed gas cylinders for Bunsen burners, gas chromatographs, and anaerobic chambers. Use cylinder-securement and compatible regulator fittings.

Anaerobic Chamber
Enclosed workstation for growing anaerobic microbes with inert gas atmosphere. Used in microbiology and fermentation work; requires monitoring and maintenance of gas mix and seals.

Vacuum Oven
Oven that dries samples or cures materials under reduced pressure to remove solvents at lower temperatures. Ideal for moisture-sensitive compounds and polymer processing.

Laminar Flow Hood (Class I/II variance)
Provides particle-free environment for assembly and handling of sterile components; differs from biosafety cabinets in airflow pattern and protection type. Select per application needs.

Orbital Incubator
Combines uniform temperature control with orbital shaking to culture microbes and cells efficiently. Useful for protein expression and growth studies; secure lids to prevent spills.

